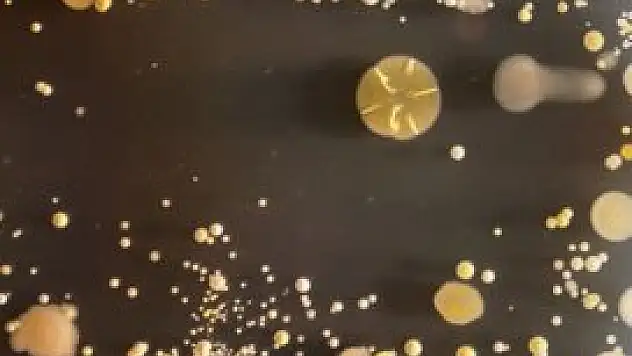
Akıllı telefonlardaki tehlike!

Gündem
Gündeme dair tüm güncel haberleri, son dakika gündem haberlerini, gündemdeki sıcak gelişmeleri tüm ayrıntılarıyla Yeni Haber'den öğrenin!

'Bize her imkanı sağladılar'

Necmettin Erbakan Ereğli'de anıldı

Devletten alacakları paradan haberleri yok

'Konya’lı sanayiciler yeni pazarlar keşfetmeli'

'Sabahtan akşama kadar işkence gördüm'

Ereğli'de çiftçilere bilgilendirme toplantısı

Kızlarda sigara içme oranı erkekleri geçti

Hollanda'da sağlık hizmetlerini anlattı

Yurtkur Konya Bölge Müdürü'ne veda yemeği

En büyük tatlı su gölünde su seviyesi yükseldi

Birinci sınıfa ayrılan hakim ve savcılar açıklandı

Hibeyi de telefonla alıyorlar

Almanya Büyükelçiliği Tarım Başkanı'ndan ziyaret

Mahmutlar Belediye başkanı adliyede

KMÜ Karakalem Topluluğu’ndan sergi

Özel Medline Konya Hastanesi’ne ziyaret

3. Köprüden bu tarihte geçeceksiniz

28 Şubat'ta yeni tutuklama!

'Milliyetçilik anlayışımız kafatasçılık değil'

Türkiye'nin milli helikopterine tam not

Beyşehir itfaiyesi'nden yangın tatbikatı

Karatay Sosyal Bilimler Lisesi kütüphanesi zenginleştirildi

'28 Şubat en ağır darbelerden biridir'

Kadın çiftçiler yarışıyor

Selçuklu Hanımlar Lokali’nden “Nevbahar” Sergisi

''Dayatmalar asla bin yıl süremez''

Maliye çalışanlarından iş bırakma eylemi

Kulu'da adliye çalışanlarından eylem

Konya'da elektrik kesintisi

İş bırakma eylemine Konya'dan destek

Mutluluk parada mı sağlıkta mı?

Engellilerin tercih maratonu başlıyor

İkinci cemre düştü

Mehmet Şamil Şenalp açıklamalarda bulundu

Beyhekim’den üç üniversiteye destek

NEÜ Türkiye’de ilk 10 dünyada il 500’ü hedefliyor

Kara leke: 28 Şubat

KOP Üniversiteler Birliği çalışmalarını hızlandırdı
Akıllı telefonlardaki tehlike!

28 Şubat'ta 3 gözaltı











